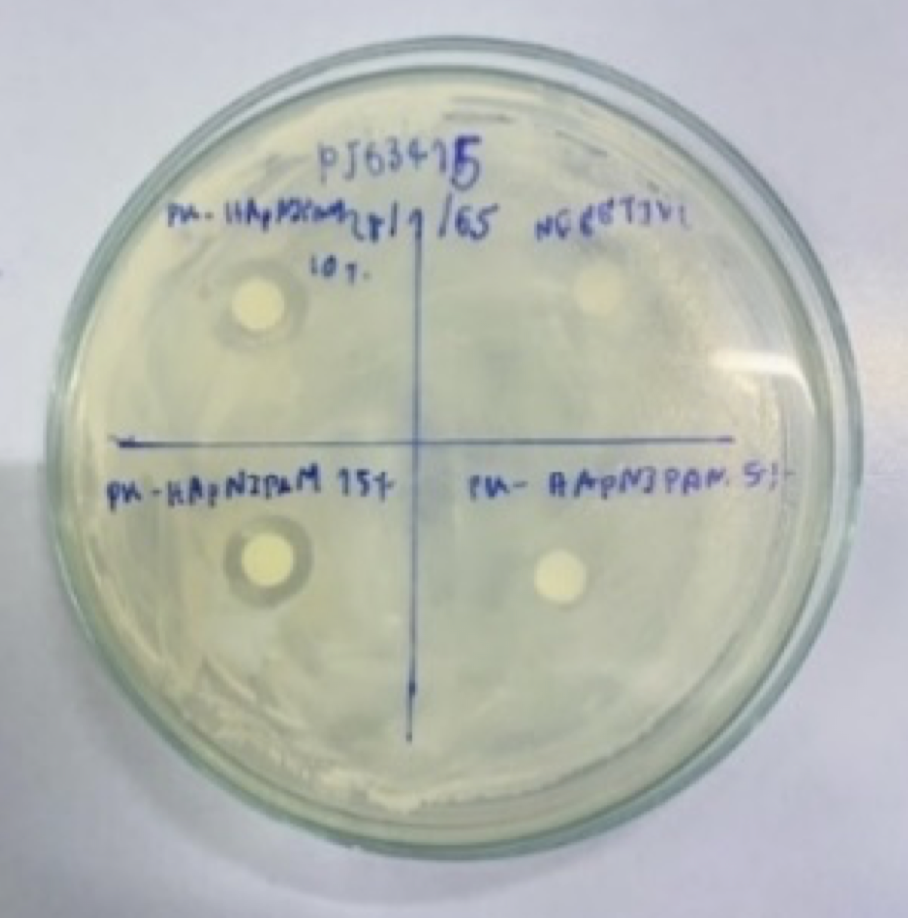

Vol 3
January - December, 2022

Article 1
Kneading and Gluten Formation in Dough
การเกิดกลูเตนจากการนวดแป้งสาลี
by Phitawat Aramratsameekul and Supawan Huangchang

Article 1
Kneading and Gluten Formation in Dough
การเกิดกลูเตนจากการนวดแป้งสาลี
by Phitawat Aramratsameekul and Supawan Huangchang

Article 2
Treatment of Subcutaneous Infections With Plu Kao Extract in Nanogel
การรักษาภาวะเนื้อเยื่อใต้ผิวหนังอักเสบด้วยระบบนําส่งสารสกัดจากพลูคาวในรูปแบบนาโนเจล
by Natnicha Danprakron and Pratiparn Kongkumnert
Article 2
Treatment of Subcutaneous Infections With Plu Kao Extract in Nanogel
การรักษาภาวะเนื้อเยื่อใต้ผิวหนังอักเสบด้วยระบบนําส่งสารสกัดจากพลูคาวในรูปแบบนาโนเจล
by Natnicha Danprakron and Pratiparn Kongkumnert

Article 3
Screening for Aerobic Fibrolytic Microorganisms to Produce Glucose from Waste Paper
การคั ดกรองจุลินทรีย์แอโรบิคไฟโบรไลติกเพื่อใช้ผลิตกลูโคสจากขยะประเภทกระดาษ
by Prabhawan Pakhin and Chonthicha Permrungruang

Article 3
Screening for Aerobic Fibrolytic Microorganisms to Produce Glucose from Waste Paper
การคั ดกรองจุลินทรีย์แอโรบิคไฟโบรไลติกเพื่อใช้ผลิตกลูโคสจากขยะประเภทกระดาษ
by Prabhawan Pakhin and Chonthicha Permrungruang

Article 4
Factors Affecting the Frequency Produced by Resonating Bamboo Tubes
by T. Watthapornsiri1, P. Sawangwong, Y. Sakaguchi, Y. Watanabe, M. Ishii, K. Meguro

Article 4
Factors Affecting the Frequency Produced by Resonating Bamboo Tubes
by T. Watthapornsiri1, P. Sawangwong, Y. Sakaguchi, Y. Watanabe, M. Ishii, K. Meguro

Article 5
Filtering Microplastics from Water with Lipids Extracted from Jackfruit Seeds
การดักจับไมโครพลาสติกในนํ้าด้วยสารกลุ่มไขมันของเมล็ดขนุน
by Puarisa Lathalo, Suphanwadee Maneesuphachat and Burapha Saenwan

Article 5
Filtering Microplastics from Water with Lipids Extracted from Jackfruit Seeds
การดักจับไมโครพลาสติกในนํ้าด้วยสารกลุ่มไขมันของเมล็ดขนุน
by Puarisa Lathalo, Suphanwadee Maneesuphachat and Burapha Saenwan
